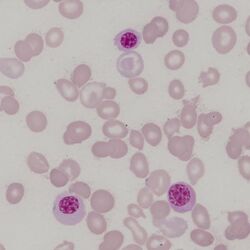

Nucleated Red Cells (nRBC)
From haematologyetc.co.uk
Derivation: descriptive term – a circulating red cell containing a nucleus
Description
Circulating erythrocytes with cytoplasmic features of mature or maturing (polychromatic) cells but containing a nucleus. Most commonly these are very late in the development stage, but may include earlier developing red cell forms where recognition can be more challenging (see images).
Appearance Individual nucleated red cells. These are difficult cells to illustrate with a single image since the size, and appearance of both cytoplasm and nucleus vary with cell maturity – recognition generally depends on identifying typical cytoplasmic appearance (a varying red hue that depends on the amount of haemoglobin and developmental stage) and the typically round and dense nucleus of later stages. Often the cause of the circulating nucleated forms will be shown by the accompanying cells – in the drawn example there is a teardrop form as well as a polychromatic cell (note the very similar cytoplasmic colour to the nucleated cell). The clinical examples also shows misshapen red cells and polychromasia.
Significance
The presence of nucleated red cells is usually highly significant, and therefore should always provoke a careful examination for a pathological cause. Rarely, nucleated erythrocytes may circulate in normal individuals, particularly during pregnancy, but should be very infrequent.
Numerous nucleated red cells may be seen where haematopoiesis is very active - in these cases an underlying cause should be readily apparent. Where there is no obvious physiological stimulus for increased red cell production, an active search should be made for features of marrow infiltration - in particular for evidence of other circulating precursor cells (leukoerythroblastic film), or for the presence of dyserythropoietic features that may indicate disordered erythropoiesis.
Pitfalls
Late typical nucleated red cells are usually easily recognised by their haemoglobin-containing cytoplasm and dense round nucleus; however earlier forms have blue cytoplasm and may be difficult to distinguish from lymphocytes. In general, circulating early nucleated erythrocytes will be accompanied by later forms which should make recognition easier.
Causes
| NORMAL INDIVIDUALS |
|---|
| 1. Physiological: including normal individuals (very infrequent), pregnancy (infrequent), neonates (frequent). More common in hyposplenic states |
| 2. Stressed haematopoiesis: response to severe bleeding or haemolysis; following haematinic replacement in severe deficiency |
| 3. Severe illness: in very severe illness or terminal events, nucleated red cells may circulate with white cell precursor cells (leukoerythroblastic film) |
| PATHOLOGICAL STATES |
| 1. Infiltrated bone marrow: consider leukaemia, myelofibrosis or infiltrating solid tumour (look also for white cell precursor cells) |
| 2. Erythroid expansion: haemoglobinopathy (particularly thalassaemia); severe membrane disorder with haemolysis; dyserythropoietic anaemias |
Clinical examples
Clinical image 1. In this case the cytoplasm of this late nucleated erythrocyte is almost identical in colour and size to the surrounding mature erythrocytes. The nucleus is very dense, round, and at the point of extrusion. Other red cells have abnormal shape, and platelets are reduced. Disorder: myelodysplasia
Clinical image 2. Three very similar nucleated red cells with typical appearance of their nuclei. Some variation of size and shape is seen between the nucleated red cells - which is fairly typical. A clue to their origin is the very abnormal red cells in the background and an absence of platelets. Clinical disorder: myelodysplasia with marrow fibrosis
Clinical image 3. There are two erythroid precursors on the background of very abnormal erythroid cells and platelets – one very late form resembles a slightly polychromatic erythrocyte with a dense round nucleus. Also present is a large cell with primitive nuclear chromatin and nucleoli. This is an early erythroblast – recognisable by the very blue cytoplasm (packed with haemoglobin-synthesising ribosomes). Clinical disorder: myelofibrosis
Pathobiology
The development of erythrocytes requires protein synthesis to produce haemoglobin and other proteins, this requires the presence of a nucleus for gene transcription but also ribosomes to translate mRNA to protein – this is reflected in the blue-tinged cytoplasm (the presence of ribosomes). The process of red cell maturation takes place in bone marrow, and cells that retain their nucleus do not generally circulate. However, they can be released during “stressed haematopoiesis” where greater red cell production is needed (for example in response to haemolysis or haemolytic anaemia) or may be displaced from bone marrow that is infiltrated (for example by solid tumour or by leukaemia). Generally, circulating nucleated cells will be late forms with dense nuclei and haemoglobin-rich cytoplasm, but in more severe conditions earlier forms may be seen.